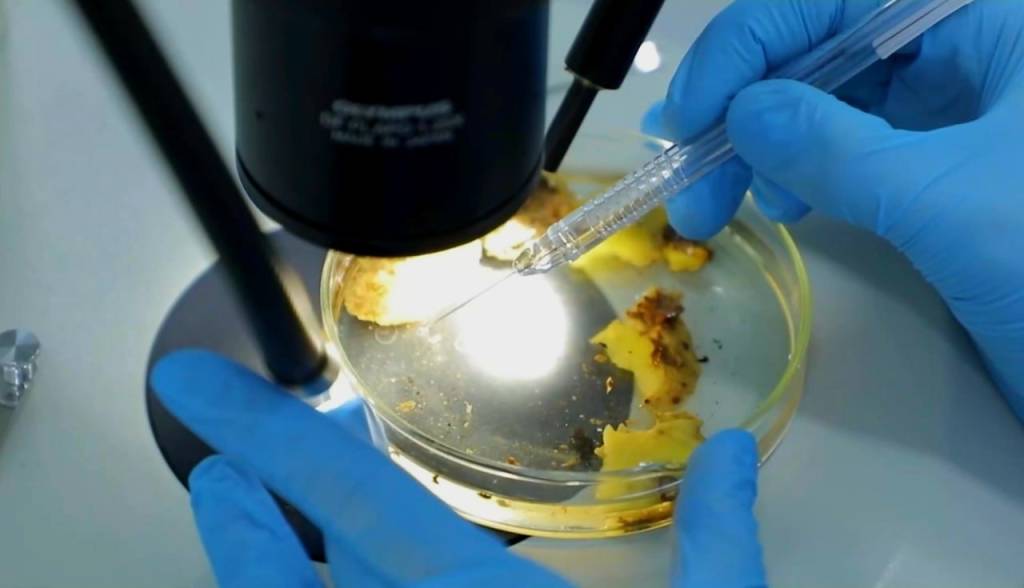

Hushyorlik har sohada zarur

Mamlakatimiz hududiga olib kirilayotgan turli ko‘chatlar va urug‘larning xavfsizligini ta’minlash bugungi kunning dolzarb vazifalardan biri hisoblanadi.
Chet mamlakatlardan turli zararli ko‘chatlarning noqonuniy kirib kelishi o‘simlik dunyosi va qishloq xo‘jaligi ekinlariga jiddiy xavf tug‘diradi.

Andijon viloyati O‘simliklar karantini va himoyasi boshqarmasi tomonidan ana shunday holatlarning oldini olish borasida doimiy nazorat tadbirlari olib borilmoqda.
Xususan, Gollandiya davlatidan yuk avtotransporti karantin davlat inspektorlari hamda bojxona xodimlari tomonidan ko‘rikdan o‘tkazilganida, yuk hujjatlarida ko‘rsatilmagan 1000 dona “Liliya” gul piyozboshlari mavjudligi aniqlandi.

– Mazkur qonunbuzarlik holati bo‘yicha gul ko‘chatlarini olib kelayotgan tadbirkorga tushuntirishlar berildi. Yurtimizga noqonuniy olib kelingan gul piyozlari tegishli tashkilotlar vakillari ishtirokida maxsus pechda yoqish yo‘li bilan yo‘q qilindi. Yana bir holatda, Italiya davlatidan import qilingan turli xil manzarali daraxt va gul ko‘chatlari Andijon TIF inspektorlari tomonidan ikkilamchi karantin ko‘rigidan o‘tkazilib, belgilangan tartib asosida namunalar markaziy fitosanitar laboratoriyasiga yuborilgan. Laboratoriya xulosasiga ko‘ra, 200 dona atirgul ko‘chatlarida respublikamiz hududida uchramaydigan “danak mevali daraxtlarning nekrotik dog‘lanish”i kasalligi aniqlangan. Karantin xodimlari tomonidan ana shu ko‘chatlar ham belgilangan tartibda yo‘q qilindi, – deydi Andijon viloyati O‘simliklar karantini va himoyasi boshqarmasi Matbuot xizmati rahbari Ulug‘bek Ahmedov.

2018-yilda qabul qilingan O‘zbekiston Respublikasining “O‘simliklar karantini to‘g‘risida”gi qonuniga muvofiq yurtimizga olib kirilayotgan va olib chiqilayotgan yoki tranzit tarzida o‘tkazilayotgan barcha mahsulotlar karantin ob’ektlaridan holi va ularning har bir turkumi fitosanitariya sertifikatlari bilan ta’minlangan bo‘lishi va fitosanitar tekshiruvlaridan o‘tkazilishi lozim.
O‘simliklar karantini bilan bog‘liq talablar nafaqat qonuniy majburiyat, balki mamlakatimiz oziq-ovqat va ekologik xavfsizligini ta’minlashning muhim omilidir.
Faxriddin Ubaydullayev, O‘zA muxbiri.



